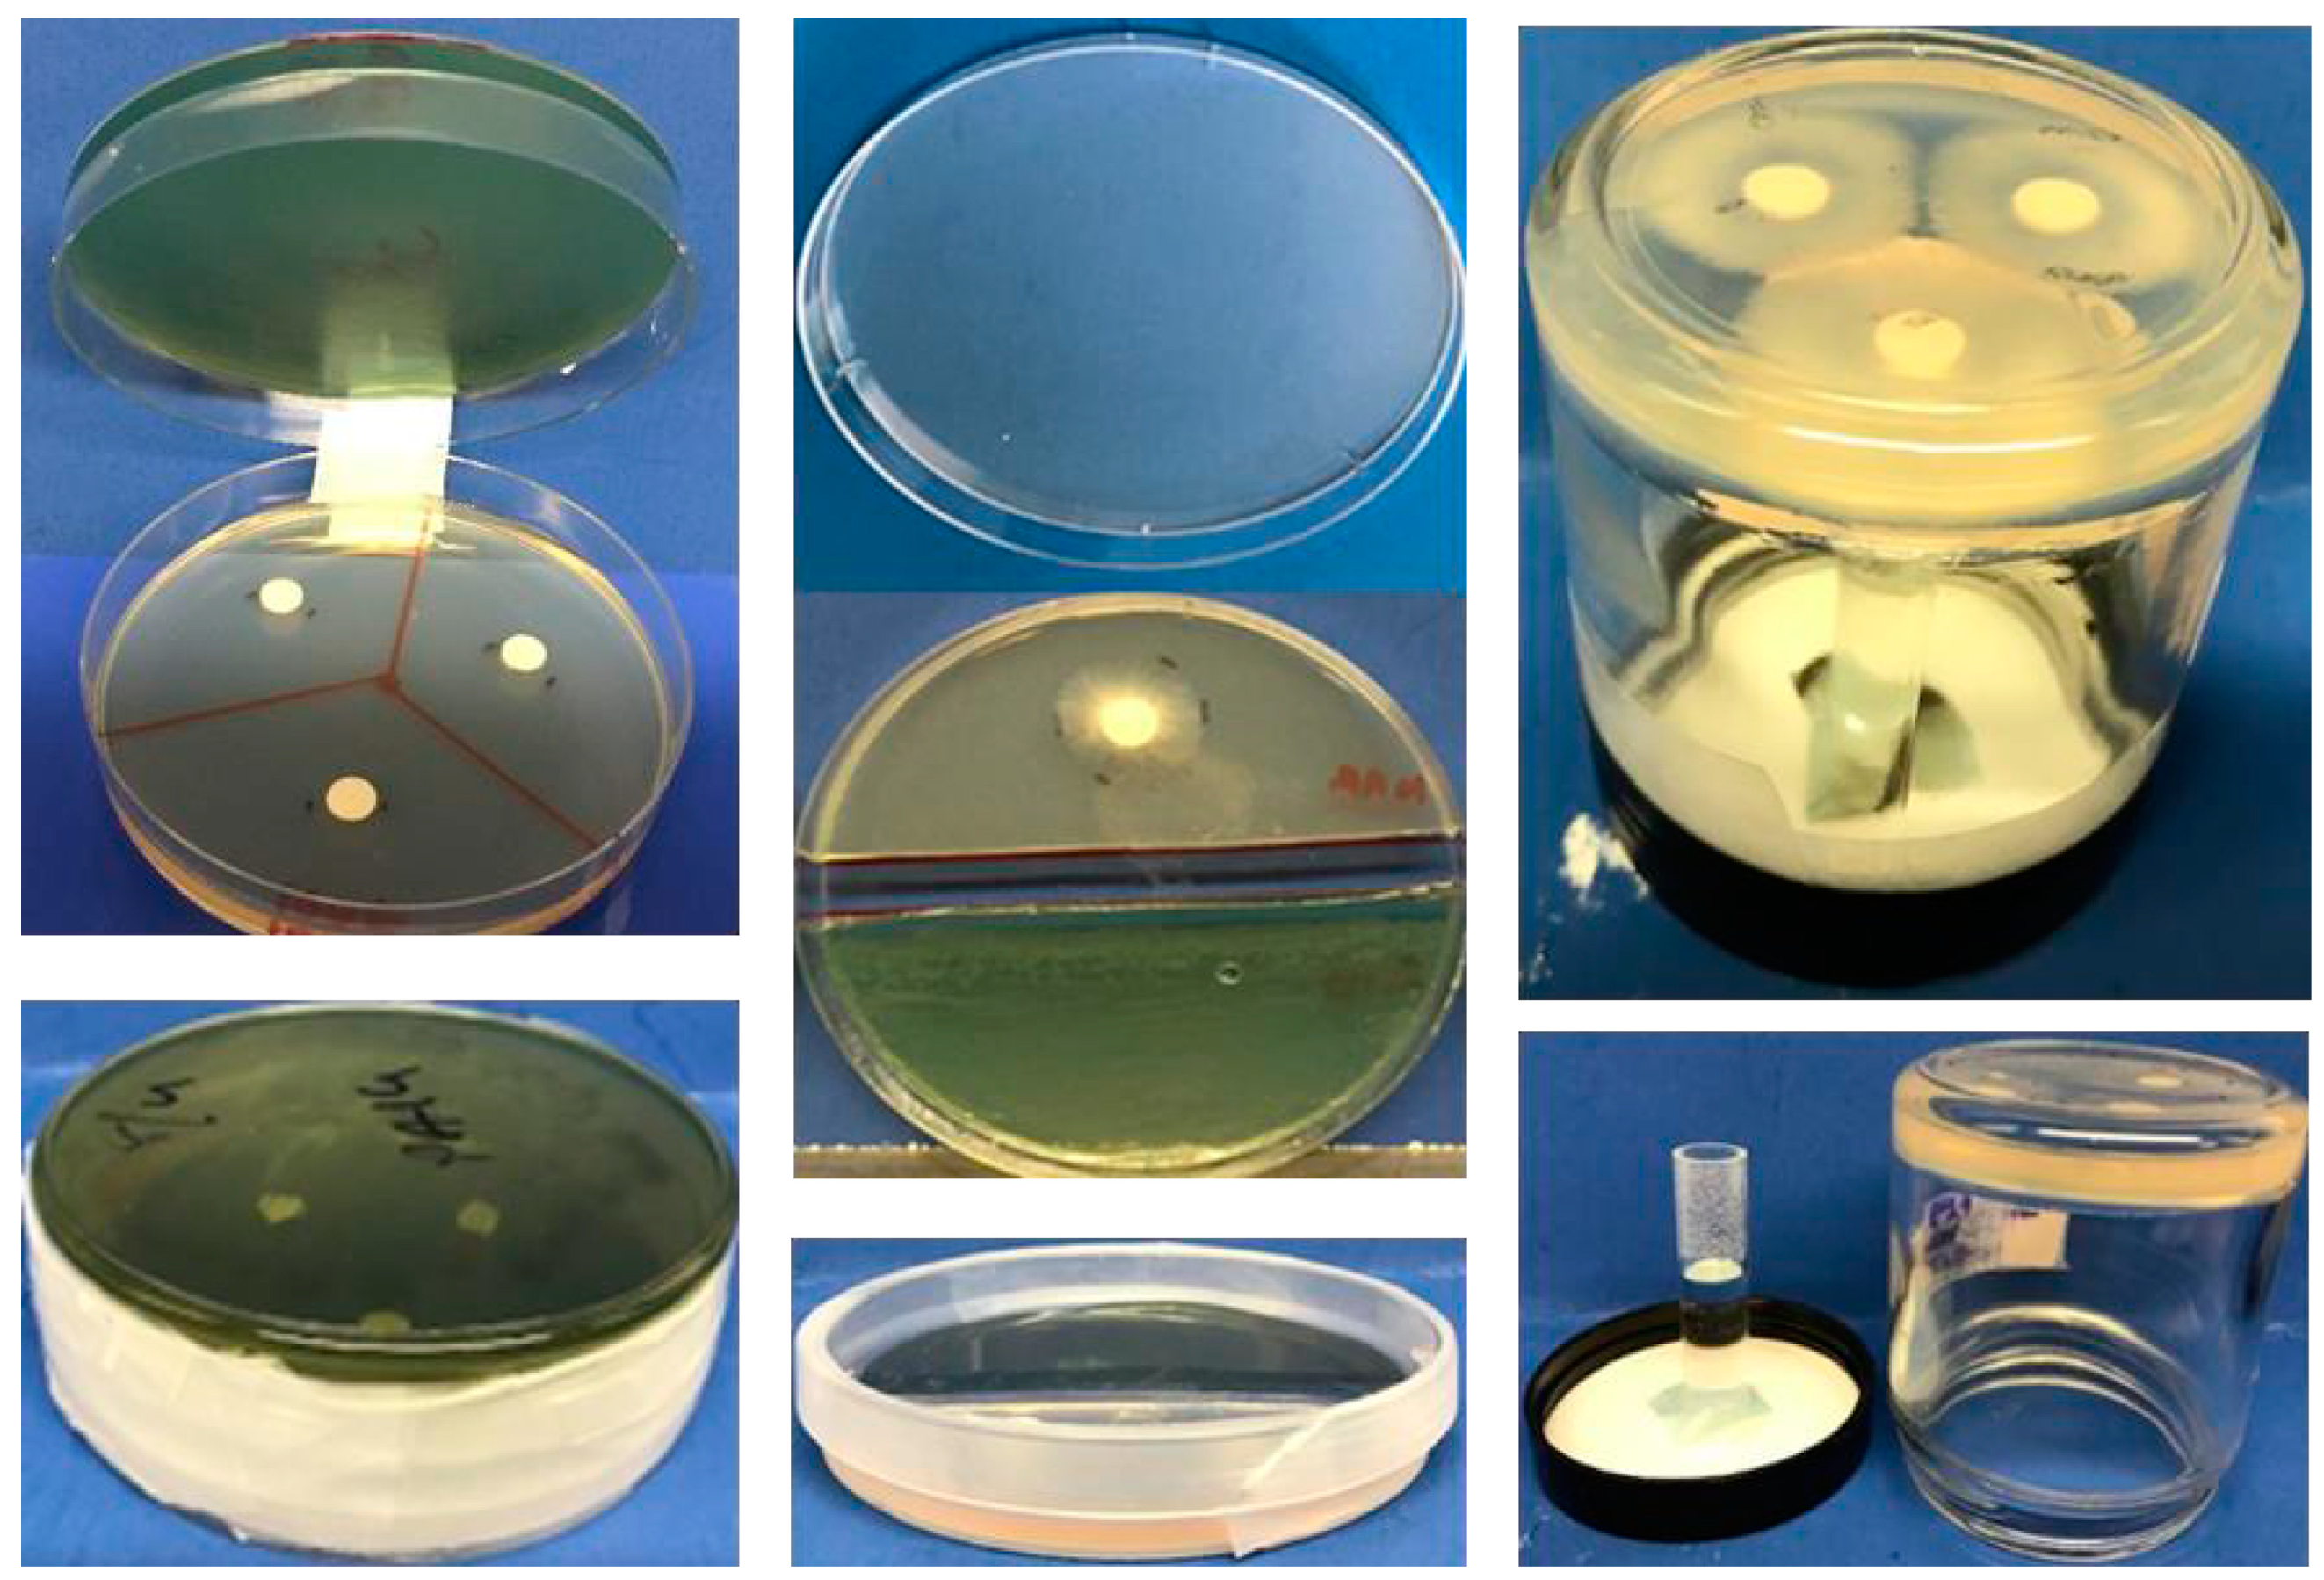
Jof 06 00118 g001 Jof 06 00118 g001

Aspergillus Is Inhibited by Pseudomonas aeruginosa Volatiles
Abstract
1. Introduction
2. Materials and Methods
2.1. Materials
2.2. Isolates
2.3. Methods for Pseudomonas Volatile Production
2.4. Methods for Pseudomonas Volatile Transfer
2.5. Preparation of Samples for Mass Spectroscopy Analysis
2.6. Identification of Volatiles
2.7. Statistical Analysis
3. Results
3.1. Effect of Assay Methods
3.2. Effect of Agar Substrates on Production of, and Assay of, Pa Volatiles
3.3. Inhibition Occurs with Several Pa or Af Strains
3.4. On the Mechanism of Inhibition
3.4.1. Inhibition Is Proportional to Pa Inoculum
3.4.2. Studies of Time of Exposure, Reversibility of Inhibition
3.4.3. Continuous Production of Pa Volatiles in the Presence of Af is not Necessary for Inhibition
3.4.4. Mechanism of Inhibition
3.5. Study of Pa Mutants
3.6. Study of Clinical Isolates
3.7. Is Inhibition by Pa Volatiles Restricted to A. fumigatus?
3.8. Contrast with Reports That Pa Volatiles Stimulate Af
3.9. Capturing of Volatiles in Liquid
3.9.1. Effect of Trapping Materials
3.9.2. Effect of Time of Exposure of Af
3.9.3. Effect of Duration of Trapping
3.9.4. Efficacious Trapping of Volatiles
3.10. Storing Trapped Volatiles for Mass Spectroscopy
3.11. Mass Spectroscopy of Inhibitory Materials
3.12. Studies of Molecules of Intense Interest as Inhibitory Volatiles
3.13. Combinations of Inhibitory Molecules
4. Discussion
Supplementary Materials
Author Contributions
Funding
Acknowledgments
Conflicts of Interest
References
- De Bentzmann, S.; Plésiat, P. The Pseudomonas aeruginosa opportunistic pathogen and human infections. Environ. Microbiol. 2011, 13, 1655–1665. [Google Scholar] [CrossRef] [PubMed]
- Latgé, J.P. Aspergillus fumigatus and aspergillosis. Clin. Microbiol. Rev. 1999, 12, 310–350. [Google Scholar] [CrossRef] [PubMed]
- Lamont, I.L.; Konings, A.F.; Reid, D.W. Iron acquisition by Pseudomonas aeruginosa in the lungs of patients with cystic fibrosis. BioMetals 2009, 22, 53–60. [Google Scholar] [CrossRef] [PubMed]
- Hogardt, M.; Heesemann, J. Adaptation of Pseudomonas aeruginosa during persistence in the cystic fibrosis lung. Int. J. Med. Microbiol. 2010, 300, 557–562. [Google Scholar] [CrossRef]
- Lipuma, J.J. The changing microbial epidemiology in cystic fibrosis. Clin. Microbiol. Rev. 2010, 23, 299–323. [Google Scholar] [CrossRef]
- Williams, H.D.; Davies, J.C. Basic science for the chest physician: Pseudomonas aeruginosa and the cystic fibrosis airway. Thorax 2012, 67, 465–467. [Google Scholar] [CrossRef]
- Folkesson, A.; Jelsbak, L.; Yang, L.; Johansen, H.K.; Ciofu, O.; Høiby, N.; Molin, S. Adaptation of Pseudomonas aeruginosa to the cystic fibrosis airway: An evolutionary perspective. Nat. Rev. Microbiol. 2012, 10, 841–851. [Google Scholar] [CrossRef]
- Fothergill, J.L.; Walshaw, M.J.; Winstanley, C. Transmissible strains of Pseudomonas aeruginosa in cystic fibrosis lung infections. Eur. Resp. J. 2012, 40, 227–237. [Google Scholar] [CrossRef]
- Konings, A.F.; Martin, L.W.; Sharples, K.J.; Roddam, L.F.; Latham, R.; Reid, D.W.; Lamont, I.L. Pseudomonas aeruginosa uses multiple pathways to acquire iron during chronic infection in cystic fibrosis lungs. Infect Immun. 2013, 81, 2697–2704. [Google Scholar] [CrossRef]
- Sabino, R.; Ferreira, J.A.; Moss, R.B.; Valente, J.; Veríssimo, C.; Carolino, E.; Clemons, K.V.; Everson, C.; Banaei, N.; Penner, J.; et al. Molecular epidemiology of Aspergillus collected from cystic fibrosis patients. J. Cyst. Fibros. 2015, 14, 474–481. [Google Scholar] [CrossRef]
- Forsyth, K.D.; Hohmann, A.W.; Martin, A.J.; Bradley, J. IgG antibodies to Aspergillus fumigatus in cystic fibrosis: A laboratory correlate of disease activity. Arch Dis. Child. 1988, 63, 953–957. [Google Scholar] [CrossRef]
- Nicolai, T.; Arleth, S.; Spaeth, A.; Bertele-Harms, R.M.; Harms, H.K. Correlation of IgE antibody titer to Aspergillus fumigatus with decreased lung function in cystic fibrosis. Pediatr. Pulmonol. 1990, 8, 12–15. [Google Scholar] [CrossRef] [PubMed]
- Salunkhe, P.; Smart, C.H.M.; Morgan, J.A.W.; Panagea, S.; Walshaw, M.J.; Hart, C.A.; Geffers, R.; Tümmler, B.; Winstanley, C. A cystic fibrosis epidemic strain of Pseudomonas aeruginosa displays enhanced virulence and antimicrobial resistance. J. Bacteriol. 2005, 187, 4908–4920. [Google Scholar] [CrossRef] [PubMed]
- Shoseyov, D.; Brownlee, K.G.; Conway, S.P.; Kerem, E. Aspergillus bronchitis in cystic fibrosis. Chest 2006, 130, 222–226. [Google Scholar] [CrossRef] [PubMed]
- Pressler, T.; Frederiksen, B.; Skov, M.; Garred, P.; Koch, C.; Høiby, N. Early rise of anti-Pseudomonas antibodies and a mucoid phenotype of Pseudomonas aeruginosa are risk factors for development of chronic lung infection—A case control study. J. Cyst. Fibros. 2006, 5, 9–15. [Google Scholar] [CrossRef][Green Version]
- Amin, R.; Dupuis, A.; Aaron, S.D.; Ratjen, F. The effect of chronic infection with Aspergillus fumigatus on lung function and hospitalization in patients with cystic fibrosis. Chest 2010, 137, 171–176. [Google Scholar] [CrossRef]
- Fillaux, J.; Brémont, F.; Murris, M.; Cassaing, S.; Rittié, J.L.; Tétu, L.; Segonds, C.; Abbal, M.; Bieth, E.; Berry, A.; et al. Assessment of Aspergillus sensitization or persistent carriage as a factor in lung function impairment in cystic fibrosis patients. Scand. J. Infect. Dis. 2012, 44, 842–847. [Google Scholar] [CrossRef]
- Speirs, J.J.; van der Ent, C.K.; Beekman, J.M. Effects of Aspergillus fumigatus colonization on lung function in cystic fibrosis. Curr. Opin. Pulm. Med. 2012, 18, 632–638. [Google Scholar] [CrossRef]
- Gaspar, M.C.; Couet, W.; Olivier, J.-C.; Pais, A.A.C.C.; Sousa, J.J.S. Pseudomonas aeruginosa infection in cystic fibrosis lung disease and new perspectives of treatment: A review. Eur. J. Clin. Microbiol. Infect. Dis. 2013, 32, 1231–1252. [Google Scholar] [CrossRef]
- Mayer-Hamblett, N.; Ramsey, B.W.; Kulasekara, H.D.; Wolter, D.J.; Houston, L.S.; Pope, C.E.; Kulasekara, B.R.; Armbruster, C.R.; Burns, J.L.; Retsch-Bogart, G.; et al. Pseudomonas aeruginosa phenotypes associated with eradication failure in children with cystic fibrosis. Clin. Infect. Dis. 2014, 59, 624–631. [Google Scholar] [CrossRef]
- Beauvais, A.; Schmidt, C.; Guadagnini, S.; Roux, P.; Perret, E.; Henry, C.; Paris, S.; Mallet, A.; Prévost, M.C.; Latgé, J.P. An extracellular matrix glues together the aerial-grown hyphae of Aspergillus fumigatus. Cell. Microbiol. 2007, 9, 1588–1600. [Google Scholar] [CrossRef] [PubMed]
- Yang, L.; Haagensen, J.A.; Jelsbak, L.; Johansen, H.K.; Sternberg, C.; Høiby, N.; Molin, S. In situ growth rates and biofilm development of Pseudomonas aeruginosa populations in chronic lung infections. J. Bacteriol. 2008, 190, 2767–2776. [Google Scholar] [CrossRef] [PubMed]
- Seidler, M.J.; Salvenmoser, S.; Müller, F.M. Aspergillus fumigatus forms biofilms with reduced antifungal drug susceptibility on bronchial epithelial cells. Antimicrob. Agents Chemother. 2008, 52, 4130–4136. [Google Scholar] [CrossRef] [PubMed]
- Bjarnsholt, T.; Jensen, P.Ø.; Fiandaca, M.J.; Pedersen, J.; Hansen, C.R.; Andersen, C.B.; Pressler, T.; Givskov, M.; Høiby, N. Pseudomonas aeruginosa biofilms in the respiratory tract of cystic fibrosis patients. Pediatr. Pulmonol. 2009, 44, 547–558. [Google Scholar] [CrossRef] [PubMed]
- Davies, J.C.; Bilton, D. Bugs, biofilms, and resistance in cystic fibrosis. Respir. Care 2009, 54, 628–640. [Google Scholar] [CrossRef] [PubMed]
- Smyth, A.R.; Hurley, M.N. Targeting the Pseudomonas aeruginosa biofilm to combat infections in patients with cystic fibrosis. Drugs Future 2010, 35, 1007–1014. [Google Scholar] [CrossRef]
- Loussert, C.; Schmitt, C.; Prevost, M.C.; Balloy, V.; Fadel, E.; Philippe, B.; Kauffmann-Lacroix, C.; Latgé, J.P.; Beauvais, A. In vivo biofilm composition of Aspergillus fumigatus. Cell. Microbiol. 2010, 12, 405–410. [Google Scholar] [CrossRef]
- Müller, F.M.; Seidler, M.; Beauvais, A. Aspergillus fumigatus biofilms in the clinical setting. Med. Mycol. 2011, 49, 96–100. [Google Scholar] [CrossRef]
- Manavathu, E.K.; Vager, D.L.; Vazquez, J.A. Development and antimicrobial susceptibility studies of in vitro monomicrobial and polymicrobial biofilm models with Aspergillus fumigatus and Pseudomonas aeruginosa. BMC Microbiol. 2014, 14, 53. [Google Scholar] [CrossRef]
- Beauvais, A.; Fontaine, T.; Aimanianda, V.; Latge, J.P. Aspergillus cell wall and biofilm. Mycopathologia 2014, 178, 371–377. [Google Scholar] [CrossRef]
- Kaur, S.; Singh, S. Biofilm formation by Aspergillus fumigatus. Med. Mycol. 2014, 52, 2–9. [Google Scholar] [PubMed]
- Beauvais, A.; Latgé, J.P. Aspergillus biofilm in vitro and in vivo. Microbiol. Spectr. 2015, 3. [Google Scholar] [CrossRef] [PubMed]
- Reichhardt, C.; Ferreira, J.A.; Joubert, L.M.; Clemons, K.V.; Stevens, D.A.; Cegelski, L. Analysis of the Aspergillus fumigatus biofilm extracellular matrix by solid-state nuclear magnetic resonance spectroscopy. Eukaryot. Cell 2015, 14, 1064–1072. [Google Scholar] [CrossRef]
- Joubert, L.M.; Ferreira, J.A.G.; Stevens, D.A.; Nazik, H.; McDonald, K.L.; Cegelski, L. Visualization of Aspergillus fumigatus biofilms with SEM (scanning electron microscopy) and VP-SEM (Variable Pressure-SEM): A comparison of processing techniques. J. Microbiol. Methods 2017, 132, 46–55. [Google Scholar] [CrossRef] [PubMed]
- Reece, E.; Segurado, R.; Jackson, A.; McClean, S.; Renwick, J.; Greally, P. Co-colonisation with Aspergillus fumigatus and Pseudomonas aeruginosa is associated with poorer health in cystic fibrosis patients: An Irish registry analysis. BMC Pulm. Med. 2017, 17, 70. [Google Scholar] [CrossRef] [PubMed]
- Mangan, A. Interactions between some aural Aspergillus species and bacteria. J. Gen. Microbiol. 1969, 58, 261–266. [Google Scholar] [CrossRef]
- Blyth, W.; Forey, A. The influence of respiratory bacteria and their biochemical fractions on Aspergillus fumigatus. Med. Mycol. 1971, 9, 273–282. [Google Scholar] [CrossRef]
- Mowat, E.; Rajendran, R.; Williams, C.; McCulloch, E.; Jones, B.; Lang, S.; Ramage, G. Pseudomonas aeruginosa and their small diffusible extracellular molecules inhibit Aspergillus fumigatus biofilm formation. FEMS Microbiol. Lett. 2010, 313, 96–102. [Google Scholar] [CrossRef]
- Tashiro, Y.; Yawata, Y.; Toyofuku, M.; Uchiyama, H.; Nomura, N. Interspecies interaction between Pseudomonas aeruginosa and other microorganisms. Microb. Environ. 2013, 28, 13–24. [Google Scholar] [CrossRef]
- Ferreira, J.A.G.; Penner, J.; Moss, R.B.; Haagensen, J.A.J.; Clemons, K.V.; Spormann, A.M.; Nazik, H.; Cohen, K.; Banaei, N.; Carolino, E.; et al. Inhibition of Aspergillus fumigatus and its biofilm by Pseudomonas aeruginosa is dependent on the source, phenotype and growth conditions of the bacterium. PLoS ONE 2015, 10, e0134692. [Google Scholar] [CrossRef]
- Briard, B.; Bomme, P.; Lechner, B.E.; Mislin, G.L.; Lair, V.; Prévost, M.C.; Latgé, J.P.; Haas, H.; Beauvais, A. Pseudomonas aeruginosa manipulates redox and iron homeostasis of its microbiota partner Aspergillus fumigatus via phenazines. Sci. Rep. 2015, 5, 8220. [Google Scholar] [CrossRef] [PubMed]
- Shirazi, F.; Ferreira, J.A.; Stevens, D.A.; Clemons, K.V.; Kontoyiannis, D.P. Biofilm filtrates of Pseudomonas aeruginosa strains isolated from cystic fibrosis patients inhibit preformed Aspergillus fumigatus biofilms via apoptosis. PLoS ONE 2016, 11, e0150155. [Google Scholar] [CrossRef] [PubMed]
- Anand, R.; Clemons, K.V.; Stevens, D.A. Effect of anaerobiasis or hypoxia on Pseudomonas aeruginosa inhibition of Aspergillus fumigatus biofilm. Arch. Microbiol. 2017, 199, 881–890. [Google Scholar] [CrossRef] [PubMed]
- Nazik, H.; Moss, R.B.; Karna, V.; Clemons, K.V.; Banaei, N.; Cohen, K.; Choudhary, V.; Stevens, D.A. Are cystic fibrosis Aspergillus fumigatus isolates different? Intermicrobial interactions with Pseudomonas. Mycopathologia 2017, 182, 315–318. [Google Scholar] [CrossRef]
- Sass, G.; Nazik, H.; Penner, J.; Shah, H.; Ansari, S.R.; Clemons, K.V.; Groleau, M.-C.; Dietl, A.-M.; Visca, P.; Haas, H.; et al. Studies of Pseudomonas aeruginosa mutants indicate pyoverdine as the central factor in inhibition of Aspergillus fumigatus biofilm. J. Bacteriol. 2018, 200, e00345-17. [Google Scholar] [CrossRef]
- Anand, R.; Moss, R.B.; Sass, G.; Banaei, N.; Clemons, K.V.; Martinez, M.; Stevens, D.A. Small colony variants of Pseudomonas aeruginosa display heterogeneity in inhibiting Aspergillus fumigatus biofilm. Mycopathologia 2018, 183, 263–272. [Google Scholar] [CrossRef]
- Reece, E.; Doyle, S.; Greally, P.; Renwick, J.; McClean, S. Aspergillus fumigatus inhibits Pseudomonas aeruginosa in co-culture: Implications of a mutually antagonistic relationship on virulence and inflammation in the CF airway. Front. Microbiol. 2018, 9, 1205. [Google Scholar] [CrossRef]
- Kerr, J.R.; Taylor, G.W.; Rutman, A.; Høiby, N.; Cole, P.J.; Wilson, R. Pseudomonas aeruginosa pyocyanin and 1-hydroxyphenazine inhibit fungal growth. J. Clin. Pathol. 1999, 52, 385–387. [Google Scholar] [CrossRef]
- Moree, W.J.; Phelan, V.V.; Wu, C.H.; Bandeira, N.; Cornett, D.S.; Duggan, B.M.; Dorrestein, P.C. Interkingdom metabolic transformations captured by microbial imaging mass spectrometry. Proc. Natl. Acad. Sci. USA 2012, 109, 13811–13816. [Google Scholar] [CrossRef]
- Smith, K.; Rajendran, R.; Kerr, S.; Lappin, D.F.; Mackay, W.G.; Williams, C.; Ramage, G. Aspergillus fumigatus enhances elastase production in Pseudomonas aeruginosa co-cultures. Med. Mycol. 2015, 53, 645–655. [Google Scholar] [CrossRef]
- Briard, B.; Rasoldier, V.; Bomme, P.; El Aouad, N.; Guerreiro, C.; Chassagne, P.; Muszkieta, L.; Latgé, J.P.; Mulard, L.; Beauvais, A. Dirhamnolipids secreted from Pseudomonas aeruginosa modify antifungal susceptibility of Aspergillus fumigatus by inhibiting β1,3 glucan synthase activity. ISME J. 2017, 11, 1578–1591. [Google Scholar] [CrossRef] [PubMed]
- Sass, G.; Ansari, S.R.; Dietl, A.-M.; Déziel, E.; Haas, H.; Stevens, D.A. Intermicrobial interaction: Aspergillus fumigatus siderophores protect against competition by Pseudomonas aeruginosa. PLoS ONE 2019, 14, e0216085. [Google Scholar] [CrossRef]
- Sass, G.; Nazik, H.; Penner, J.; Shah, H.; Ansari, S.R.; Clemons, K.V.; Groleau, M.C.; Dietl, A.M.; Visca, P.; Haas, H.; et al. Aspergillus-Pseudomonas interaction, relevant to competition in airways. Med. Mycol. 2019, 57 (Suppl. 2), S228–S232. [Google Scholar] [CrossRef]
- Nazik, H.; Sass, G.; Ansari, S.R.; Ertekin, R.; Haas, H.; Deziel, E.; Stevens, D.A. Novel intermicrobial molecular interaction: Pseudomonas aeruginosa Quinolone Signal (PQS) modulates Aspergillus fumigatus response to iron. Microbiology 2020, 166, 44–55. [Google Scholar] [CrossRef]
- Chatterjee, P.; Sass, G.; Swietnicki, W.; Stevens, D.A. Review of potential Pseudomonas weaponry, relevant to the Pseudomonas-Aspergillus interplay, for the mycology community. J. Fungi 2020, 6, 81. [Google Scholar] [CrossRef]
- Sass, G.; Nazik, H.; Chatterjee, P.; Stevens, D.A. In high iron environment, pyocyanin is a major anti-fungal molecule; differences in prototype P. aeruginosa strains. Med. Mycol. 2020, in press. [Google Scholar]
- Briard, B.; Heddergott, C.; Latgé, J. Volatile compounds emitted by Pseudomonas aeruginosa stimulate growth of the fungal pathogen Aspergillus fumigatus. mBio 2016, 7, e00219-16. [Google Scholar] [CrossRef] [PubMed]
- He, J.; Baldini, R.L.; Deziel, E.; Saucier, M.; Zhang, Q.; Liberati, N.T.; Lee, D.; Urbach, J.; Goodman, H.M.; Rahme, L.G. The broad host range pathogen Pseudomonas aeruginosa strain PA14 carries two pathogenicity islands harboring plant and animal virulence genes. Proc. Natl. Acad. Sci. USA 2004, 101, 2530–2535. [Google Scholar] [CrossRef] [PubMed]
- Secor, P.R.; Sass, G.; Nazik, H.; Stevens, D.A. Effect of acute predation with bacteriophage on intermicrobial aggression by Pseudomonas aeruginosa. PLoS ONE 2017, 12, e0179659. [Google Scholar] [CrossRef]
- Hubschmann, H.J. Handbook of GC-MS: Fundamentals and Applications, 3rd ed.; John Wiley and Sons: Hoboken, NJ, USA, 2015. [Google Scholar]
- Lawal, O.; Knobel, H.; Weda, H.; Bos, L.D.; Nijsen, T.M.E.; Goodacre, R.; Fowler, S.J. Volatile organic compound signature from co-culture of lung epithelial cell line with Pseudomonas aeruginosa. Analyst 2018, 143, 3148–3155. [Google Scholar] [CrossRef]
- Scott, J.; Sueiro-Olivares, M.; Ahmed, W.; Heddergott, C.; Zhao, C.; Thomas, R.; Bromley, M.; Latgé, J.P.; Krappmann, S.; Fowler, S.; et al. Pseudomonas aeruginosa-derived volatile sulfur compounds promote distal Aspergillus fumigatus growth and a synergistic pathogen-pathogen interaction that increases pathogenicity in co-infection. Front. Microbiol. 2019, 10, 2311. [Google Scholar] [CrossRef] [PubMed]
- Labows, J.N.; McGinley, K.J.; Webster, G.F.; Leyden, J.J. Headspace analysis of volatile metabolites of Pseudomonas aeruginosa and related species by gas chromatography-mass spectrometry. J. Clin. Microbiol. 1980, 12, 521–526. [Google Scholar] [CrossRef]
- Zechman, J.M.; Labows, J.N., Jr. Volatiles of Pseudomonas aeruginosa and related species by automated headspace concentration—Gas chromatography. Can. J. Microbiol. 1985, 31, 232–237. [Google Scholar] [CrossRef] [PubMed]
- Bean, H.D.; Dimandja, J.M.; Hill, J.E. Bacterial volatile discovery using solid phase microextraction and comprehensive two-dimensional gas chromatography-time-of-flight mass spectrometry. J. Chromatogr. B Analyt. Technol. Biomed Life Sci. 2012, 901, 41–46. [Google Scholar] [CrossRef] [PubMed]
- Goeminne, P.C.; Vandendriessche, T.; Van Eldere, J.; Nicolai, B.M.; Hertog, M.L.; Dupont, L.J. Detection of Pseudomonas aeruginosa in sputum headspace through volatile organic compound analysis. Respir. Res. 2012, 13, 87. [Google Scholar] [CrossRef] [PubMed]
- Shestivska, V.; Spaněl, P.; Dryahina, K.; Sovová, K.; Smith, D.; Musílek, M.; Nemec, A. Variability in the concentrations of volatile metabolites emitted by genotypically different strains of Pseudomonas aeruginosa. J. Appl. Microbiol. 2012, 113, 701–713. [Google Scholar] [CrossRef] [PubMed]
- Heddergott, C.; Calvo, A.M.; Latgé, J.P. The volatome of Aspergillus fumigatus. Eukaryot. Cell 2014, 13, 1014–1025. [Google Scholar] [CrossRef]
- 68 de Heer, K.; Vonk, S.I.; Kok, M.; Kolader, M.; Zwinderman, A.H.; van Oers, M.H.; Sterk, P.J.; Visser, C.E. eNose technology can detect and classify human pathogenic molds in vitro: A proof-of-concept study of Aspergillus fumigatus and Rhizopus oryzae. J. Breath Res. 2016, 10, 036008. [Google Scholar] [CrossRef]
- de Heer, K.; Kok, M.G.; Fens, N.; Weersink, E.J.; Zwinderman, A.H.; van der Schee, M.P.; Visser, C.E.; van Oers, M.H.; Sterk, P.J. Detection of airway colonization by Aspergillus fumigatus by use of Electronic Nose Technology in patients with cystic fibrosis. J. Clin. Microbiol. 2016, 54, 569–575. [Google Scholar] [CrossRef]
- Bean, H.D.; Rees, C.A.; Hill, J.E. Comparative analysis of the volatile metabolomes of Pseudomonas aeruginosa clinical isolates. J. Breath Res. 2016, 10, 047102. [Google Scholar] [CrossRef]
- Pabary, R.; Huang, J.; Kumar, S.; Alton, E.W.; Bush, A.; Hanna, G.B.; Davies, J.C. Does mass spectrometric breath analysis detect Pseudomonas aeruginosa in cystic fibrosis? Eur. Respir. J. 2016, 47, 994–997. [Google Scholar] [CrossRef] [PubMed]
- Nasir, M.; Bean, H.D.; Smolinska, A.; Rees, C.A.; Zemanick, E.T.; Hill, J.E. Volatile molecules from bronchoalveolar lavage fluid can ‘rule-in’ Pseudomonas aeruginosa and ‘rule-out’ Staphylococcus aureus infections in cystic fibrosis patients. Sci. Rep. 2018, 8, 826. [Google Scholar] [CrossRef] [PubMed]
- Kviatkovski, I.; Shushan, S.; Oron, Y.; Frumin, I.; Amir, D.; Secundo, L.; Livne, E.; Weissbrod, A.; Sobel, N.; Helman, Y. Smelling Pseudomonas aeruginosa infections using a whole-cell biosensor—An alternative for the gold-standard culturing assay. J. Biotechnol. 2018, 267, 45–49. [Google Scholar] [CrossRef] [PubMed]
- Suarez-Cuartin, G.; Giner, J.; Merino, J.L.; Rodrigo-Troyano, A.; Feliu, A.; Perea, L.; Sanchez-Reus, F.; Castillo, D.; Plaza, V.; Chalmers, J.D.; et al. Identification of Pseudomonas aeruginosa and airway bacterial colonization by an electronic nose in bronchiectasis. Respir. Med. 2018, 136, 111–117. [Google Scholar] [CrossRef]
- Koehler, T.; Ackermann, I.; Brecht, D.; Uteschil, F.; Wingender, J.; Telgehder, U.; Schmitz, O.J. Analysis of volatile metabolites from in vitro biofilms of Pseudomonas aeruginosa with thin-film microextraction by thermal desorption gas chromatography-mass spectrometry. Analyt Bioanalyt. Chem. 2020, 412, 2881–2892. [Google Scholar] [CrossRef]
- Schmidt, R.; Cordovez, V.; de Boer, W.; Raaijmakers, J.; Garbeva, P. Volatile affairs in microbial interactions. ISME J. 2015, 9, 2329–2335. [Google Scholar] [CrossRef]
- Melkina, O.E.; Khmel, I.A.; Plyuta, V.A.; Koksharova, O.A.; Zavilgelsky, G.B. Ketones 2-heptanone, 2-nonanone, and 2-undecanone inhibit DnaK-dependent refolding of heat-inactivated bacterial luciferases in Escherichia coli cells lacking small chaperon IbpB. Appl. Microbiol. Biotechnol. 2017, 101, 5765–5771. [Google Scholar] [CrossRef]
- Ebadzadsahrai, G.; Higgins Kepler, E.A.; Soby, S.D.; Bean, H.D. Inhibition of fungal growth and induction of a novel volatilome in response to Chromobacterium vaccinii volatile organic compounds. Front. Microbiol. 2020, 11, 1035. [Google Scholar] [CrossRef]
- Gutierrez-Santa Ana, A.; Carrillo-Cerda, H.A.; Rodriguez-Campos, J.; Kirchmayr, M.R.; Contreras-Ramos, S.M.; Velazquez-Fernandez, J.B. Volatile emission compounds from plant growth-promoting bacteria are responsible for the antifungal activity against F. solani. 3 Biotech 2020, 10, 292. [Google Scholar] [CrossRef]

| dimethyl trisulfide |
| 3-methyl butanol |
| benzaldehyde |
| 4 hydroxy-4-methyl-2-pentanone |
| pentanal |
| 2-acetylthiazole |
| unknown ions at positions 41 and 57 |
| unknown C10 H20 molecule |
| acetone |
| 2-butanone |
| isoamyl alcohol |
| 2-nonanone |
| dimethyl sulfide |
| acetophenone |
| dimethyl disulfide |
| 2,5-dimethylpyrazine |
| methyl methacrylate |
| toluene |
| ethyl benzene |
| xylene isomer |
| methoxy-phenyl-oxime |
| 2-ethyl-1-hexanol |
| butylated hydroxytoluene |
| 2(-1, 1, 3, 3-tetramethylbutyl)-phenol |
| methanethiol |
| isopropyl alcohol |
| thiopavalic acid |
| 2-pentyl furan |
| 1-undecene |
| 2-amino acetophenone |
| unknown ions at positions 325 and 341 |
| unknown ions at positions 41 and 6 |
| methyl thiocyanate * |
| methyl thiobutyrate * |
| methyl thio isovalerate * |
| 2-undecanone * |
| heptane |
| mercaptoacetone |
| 5-methyl ester butane thioic acid |
| 2-heptanone |
| decanone |
| 2-undecanol |
| 2-tridecanone |
| 1-undecanol |
| 2-dodecanone |
© 2020 by the authors. Licensee MDPI, Basel, Switzerland. This article is an open access article distributed under the terms and conditions of the Creative Commons Attribution (CC BY) license (http://creativecommons.org/licenses/by/4.0/).
Share and Cite
Nazik, H.; Sass, G.; Déziel, E.; Stevens, D.A. Aspergillus Is Inhibited by Pseudomonas aeruginosa Volatiles. J. Fungi 2020, 6, 118. https://doi.org/10.3390/jof6030118
Nazik H, Sass G, Déziel E, Stevens DA. Aspergillus Is Inhibited by Pseudomonas aeruginosa Volatiles. Journal of Fungi. 2020; 6(3):118. https://doi.org/10.3390/jof6030118
Chicago/Turabian StyleNazik, Hasan, Gabriele Sass, Eric Déziel, and David A. Stevens. 2020. "Aspergillus Is Inhibited by Pseudomonas aeruginosa Volatiles" Journal of Fungi 6, no. 3: 118. https://doi.org/10.3390/jof6030118
APA StyleNazik, H., Sass, G., Déziel, E., & Stevens, D. A. (2020). Aspergillus Is Inhibited by Pseudomonas aeruginosa Volatiles. Journal of Fungi, 6(3), 118. https://doi.org/10.3390/jof6030118

